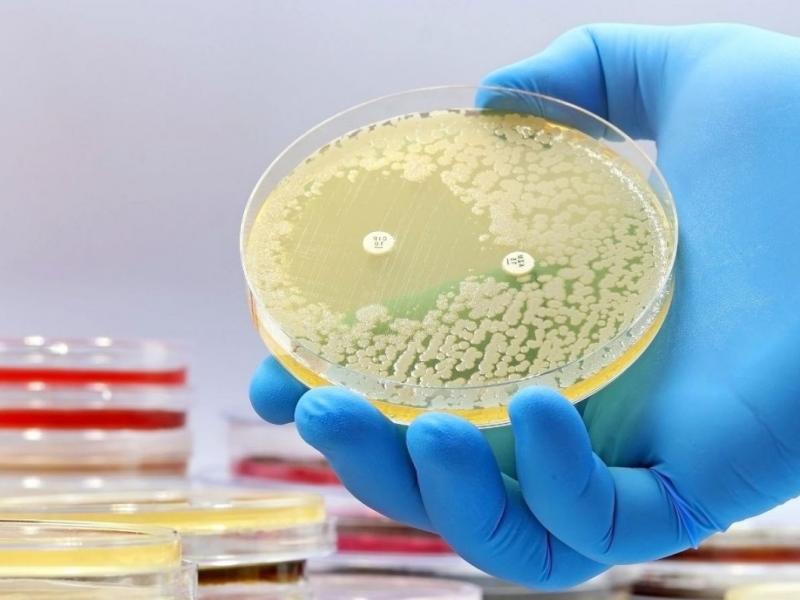
применение лабораторного технологического оборудования

Главная
›
Новости
Роль и применение лабораторного технологического оборудования в научных и промышленных целях
Опубликовано: 21.05.2024

Лабораторное технологическое оборудование играет ключевую роль в современных исследованиях и производстве. Оно представляет собой разнообразные устройства, предназначенные для проведения различных экспериментов, анализа материалов, контроля качества продукции и многих других задач. Такое оборудование используется в различных отраслях, начиная от медицины и биологии и заканчивая инженерией и химией.
Лабораторное технологическое оборудование может быть разделено на несколько категорий в зависимости от его назначения. К ним относятся аналитические приборы, спектрометры, хроматографы, микроскопы, оборудование для смешивания и перемешивания веществ, а также для термической обработки материалов.
Одним из основных преимуществ использования лабораторного технологического оборудования является возможность получения точных и надежных результатов исследований. Благодаря современным технологиям и высокой точности приборов, ученые и специалисты могут проводить сложные эксперименты и анализировать данные с высокой степенью достоверности.

Кроме того, лабораторное технологическое оборудование https://профлаб.рф/catalog/ способствует повышению эффективности производства и контролю качества продукции. Благодаря автоматизации и улучшенным технологиям, процессы производства становятся более точными и эффективными, что в конечном итоге позитивно сказывается на конечном продукте.
Таким образом, лабораторное технологическое оборудование является неотъемлемой частью современной науки и промышленности. Его роль в исследованиях и производстве неоценима, и постоянное развитие технологий в этой области способствует прогрессу в различных сферах деятельности человека.
- Какова роль лабораторного технологического оборудования в научных исследованиях?
- Лабораторное технологическое оборудование играет ключевую роль в научных исследованиях, обеспечивая возможность проведения точных экспериментов, измерений и анализа данных. Оно помогает ученым и исследователям получить надежные результаты, необходимые для развития науки и технологий.
- Какие преимущества использования лабораторного технологического оборудования в промышленности?
- В промышленности лабораторное технологическое оборудование позволяет контролировать качество продукции, оптимизировать производственные процессы, сокращать затраты и повышать эффективность производства. Оно также помогает в разработке новых продуктов и технологий.
- Какие виды лабораторного технологического оборудования наиболее часто используются в научных и промышленных целях?
- Среди наиболее часто используемого лабораторного технологического оборудования можно выделить спектрометры, хроматографы, микроскопы, анализаторы, термостаты, центрифуги, реакторы и другие устройства, специализированные для различных видов исследований и производственных процессов.
- Каковы основные требования к выбору лабораторного технологического оборудования для конкретных задач?
- При выборе лабораторного технологического оборудования необходимо учитывать цели и задачи исследования или производства, требования к точности измерений, доступный бюджет, объем работы, необходимость автоматизации процессов и другие факторы. Важно также обращать внимание на качество и надежность оборудования, а также на наличие сертификации и технической поддержки.
- Какие тенденции в развитии лабораторного технологического оборудования можно выделить в настоящее время?
- В настоящее время наблюдается тенденция к развитию более компактного, точного и автоматизированного лабораторного технологического оборудования. Также активно внедряются новые технологии, такие как цифровизация, интернет вещей (IoT), искусственный интеллект (ИИ) и другие, что позволяет улучшить производительность и результативность исследований и производства.
Это основные вопросы и ответы по теме «Роль и применение лабораторного технологического оборудования в научных и промышленных целях». Надеюсь, эта информация будет полезной для вас.